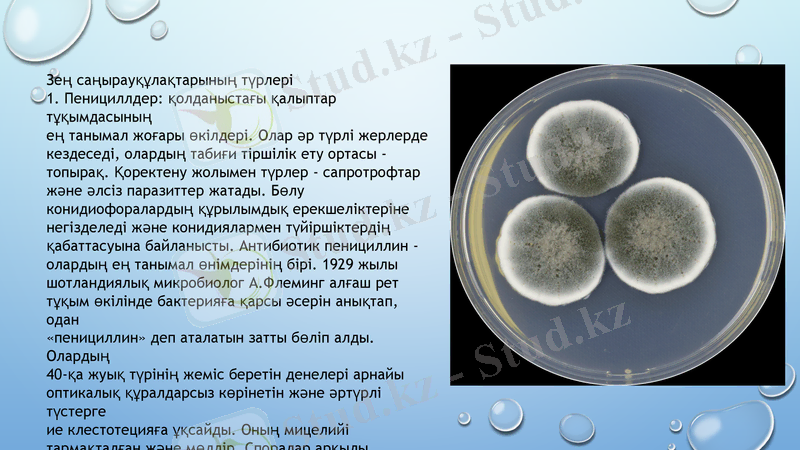
Slide 6

Саңырауқұлақтарды өсіруге арналған қоректік орталар және оларды дайындау әдістері



ҚАЗАҚСТАН РЕСПУБЛИКАСЫ БІЛІМ ЖӘНЕ ҒЫЛЫМ МИНИСТРЛІГІ
ҚАЗАҚ ҰЛТТЫҚ АГРАРЛЫҚ ЗЕРТТЕУ УНИВЕРСИТЕТІ
Микробиология, вирусология және иммунология кафедрасы
ТАҚЫРЫП: Саңырауқұлақтарды өсіру үшін қолданылатын қоректік орталар және оларды дайындау әдістері
Орындаған: Ахмет Біржан
Тексерген: Жылқайдар Арман
Топ: ВМ - 205
14 тәжірибелік сабақ.
БАКТЕРИЯЛЫҚ ИНФЕКЦИЯЛАРДЫҢ ДИАГНОСТИКАСЫ
пәнінен

Жоспар:
Кіріспе
Негізгі бөлім
Қортынды
Пайдаланылған әдебиеттер
Сабақтың мақсаты Саңырауқұлақтарды өсіруге арналған қоректік орталармен таныстыру.

Көптеген қалпақты саңырауқұлақтар ғана емес, өзге де саңырауқұлақтар кең пайдаланылып, адам мәдени дақыл ретінде өсіреді. Адамдар пайдаланатын қалпақсыз саңырауқұлақтарды екі үлкен топқа бөлуге болады:
1) зең саңырауқұлақтары антибиотиктер, оның ішінде пенициллин алуға пайдаланылады;
2) ашытқылар.
Біржасушалы ұсақ ағзалардан бактериялар кең пайдаға асырылады. Солардың жәрдемімен сан алуан витаминдер, ферменттер және басқа көптеген заттар алуға болады. Ұсақ ағзалардың негізгі сұрыптау ерекшелігі қысқа мерзімде дарақтар мен ұрпақтардың көп мөлшерін оңай алуға болатынында. Өйткені бактерия жасушасы қолайлы жағдайда әрбір 20 минут сайын көбейеді. Зертханада бір жұмыс күнінде сынақтәжірибе қойып, олардың нәтижесін көптеген ұрпактарда бақылауға мүмкіндік туады. Дәл осындай зерттеуді біржасушалы өсімдіктермен өткізу үшін көптеген жылдар және өте көп қаржы жұмсау қажет болар еді. Атап айтқанда бұл ағзалар топтарының негізгі сұрыптау әдістерінің бірі қолдан мутагенездеп, соңынан іріктеу болып табылады.
1. Кіріспе

Зең саңырауқұлақтары
Зең - микроскопиялық саңырауқұлақтар, оларды қарапайым
көзбен көру мүмкін емес.
Олардың жалпы атауы - микромицеттер - төменгі және ішінара
жоғары саңырауқұлақтар тобы. Қоректену түрі бойынша олар
сапротрофтар болып табылады. Олардың негізгі сипаттамасы -
тірі ағзалардың қалдықтарын органикалық және
бейорганикалық қосылыстарға айналдырып, өңдеу
қабілеттілігінің болуы. Сонымен қатар олардың арасында
паразиттер кездеседі, мысалы, жайылған пеницилл, алманың
бетінде жұмсақ қоңыр шірікке айналдырады.
Табиғатта таралу барлық жерде кездеседі. Биосферадағы заттар
мен энергия айналымындағы олардың маңызын асыра бағалау
қиын. Олар өмір сүру жағдайларын таңдамайды: олар үшін ең
бастысы - жылу, жоғары ылғалдылық және қоректік орта.
Олардың колониялары органикалық және бейорганикалық
заттарды зақымдап, өзіне тән дақтар түзе алады.

Зеңдерге тән қасиет - қоректік заттарда көгерудің пайда болуы. Ол
өрмекшінің торына ұқсайды, үлпілдек немесе шаңды бола алады және түрлітүсті болады. Саңырауқұлақтың атауы көбінесе дақтардың түсімен
байланысты: сұр зең, жасыл зең, қара зең және т. б. Қалыптың пішіні мен түсі
жүйелік сипаттамалар болып табылады. Көгерудің пайда болуының қажетті
шарттарының бірі қоректік субстраттың жеткілікті ылғалдылығы және
қоршаған ауаның жоғары салыстырмалы ылғалдылығы болып саналады.
Зеңдердің көп бөлігі сапрофиттер болып табылады, бірақ олардың
арасында өсімдіктердің, жануарлардың және адамның қосымша паразиттері
де бар. Олар ферменттердің өте кең спектрімен сипатталады, соның
арқасында олар әртүрлі қоректік заттармен өмір сүре алады.
Зең саңырауқұлақтарының түрлері
1. Пенициллдер: қолданыстағы қалыптар тұқымдасының
ең танымал жоғары өкілдері. Олар әр түрлі жерлерде
кездеседі, олардың табиғи тіршілік ету ортасы -
топырақ. Қоректену жолымен түрлер - сапротрофтар
және әлсіз паразиттер жатады. Бөлу
конидиофоралардың құрылымдық ерекшеліктеріне
негізделеді және конидиялармен түйіршіктердің
қабаттасуына байланысты. Антибиотик пенициллин -
олардың ең танымал өнімдерінің бірі. 1929 жылы
шотландиялық микробиолог А. Флеминг алғаш рет
тұқым өкілінде бактерияға қарсы әсерін анықтап, одан
«пенициллин» деп аталатын затты бөліп алды. Олардың
40-қа жуық түрінің жеміс беретін денелері арнайы
оптикалық құралдарсыз көрінетін және әртүрлі түстерге
ие клестотецияға ұқсайды. Оның мицелийі
тармақталған және мөлдір. Споралар арқылы көбейеді.

Микромицеттердің қолданылуы
Микромицеттер адам өзінің іс-әрекетінің көптеген салаларында қолданылады.
Олардың рөлі тамақ өнеркәсібі мен медицинада ерекше маңызды.
Саңырауқұлақтар микробиологиялық өнеркәсіпте белоктық биомасса,
ферменттер, витаминдер, органикалық қышқылдар және басқа бірқатар
биологиялық белсенді заттарды алу үшін қолданылады.
Саңырауқұлақтар қоршаған ортаға зиян келтіретін дәстүрлі технологиялардың
орнын басатын жаңа экологиялық таза энергия үнемдейтін биотехнологияларды
жасау үшін қолданылады
Мысалы, биопульпинг технологиясы - ұсақталған ағаш целлюлозасын арнайы
саңырауқұлақтармен немесе олардың ферменттерімен алдын-ала өңдеу
целлюлоза өндірісі кезінде лигнинді селективті түрде кетіруге мүмкіндік береді.
Бұл технология экологиялық тұрғыдан үйлесімді ғана емес, сонымен қатар
целлюлоза өндірісінде 30% дейін энергия үнемдейді, яғни энергияны үнемдейді

Саңырауқұлақтардың биотехнологиядағы қызметі әртүрлі. Олар келесі
өнімдерді алу үшін қолданылады:
антибиотиктер (пенициллалар, цефалоспориндер) ;
гиббереллиндер мен цитокининдер (фузариум және ботритис) ;
каротиноидтар (мысалы, лосось балықтарының етіне қызыл-қызғылт
сары рең беретін астаксантинді Rhaffia rhodozima шығарады, оны
балық зауыттарында тамақтандыру үшін қосады) ;
ақуыз (Candida, Saccharomyces lipolitica) ;
Рокфорт және Камемберт (пеницилл) сияқты ірімшіктер;
соя тұздығы (Aspergillus oryzae) .

Медицинада қолдану
Микромицеттердің көпшілік түрлерін адамдар емдік мақсатта кең қолданады. Пенициллин
антибиотикін жасау миллиондаған адамдардың денсаулығын сақтауға көмектесті. Бүгінгі таңда
олардың ең танымал және тиімді топтарының бірі - цефалоспориндер. Микробиологияның дамуы
зеңдерді химиялық мутагендермен өңдеу арқылы олардың жаңа формалары - пенициллин,
стрептомицин шығаратын және басқа антибиотиктерді көп мөлшерде шығаратын анкомицеттер
алынған сынақтарды өткізуге мүмкіндік берді.
Зеңнен алынған маңызды дәрілік заттар - холестеринді төмендету және атеросклерозды
емдеу үшін қолданылатын статиндер.
Ашытқыны медицинада қолдануда маңызды болып табылады. Құрғақ түрінде олар дәрі-дәрмектер
мен тағамдық қоспалар алу үшін, сұйық күйінде аллергияны емдеу және асқазан-ішек жолдарының
микрофлорасын қалпына келтіру үшін қолданылады.

Патогенді саңырауқұлақтар және күресу шаралары
Тұрғын үйлердің температурасы мен ылғалдылығы кейбір жағдайларда саңырауқұлақ
зеңдерінің көбеюіне және өмір сүруіне жақсы әсер етеді.
- Іс жүргізу
- Автоматтандыру, Техника
- Алғашқы әскери дайындық
- Астрономия
- Ауыл шаруашылығы
- Банк ісі
- Бизнесті бағалау
- Биология
- Бухгалтерлік іс
- Валеология
- Ветеринария
- География
- Геология, Геофизика, Геодезия
- Дін
- Ет, сүт, шарап өнімдері
- Жалпы тарих
- Жер кадастрі, Жылжымайтын мүлік
- Журналистика
- Информатика
- Кеден ісі
- Маркетинг
- Математика, Геометрия
- Медицина
- Мемлекеттік басқару
- Менеджмент
- Мұнай, Газ
- Мұрағат ісі
- Мәдениеттану
- ОБЖ (Основы безопасности жизнедеятельности)
- Педагогика
- Полиграфия
- Психология
- Салық
- Саясаттану
- Сақтандыру
- Сертификаттау, стандарттау
- Социология, Демография
- Спорт
- Статистика
- Тілтану, Филология
- Тарихи тұлғалар
- Тау-кен ісі
- Транспорт
- Туризм
- Физика
- Философия
- Халықаралық қатынастар
- Химия
- Экология, Қоршаған ортаны қорғау
- Экономика
- Экономикалық география
- Электротехника
- Қазақстан тарихы
- Қаржы
- Құрылыс
- Құқық, Криминалистика
- Әдебиет
- Өнер, музыка
- Өнеркәсіп, Өндіріс
Қазақ тілінде жазылған рефераттар, курстық жұмыстар, дипломдық жұмыстар бойынша біздің қор #1 болып табылады.



Ақпарат
Қосымша
Email: info@stud.kz